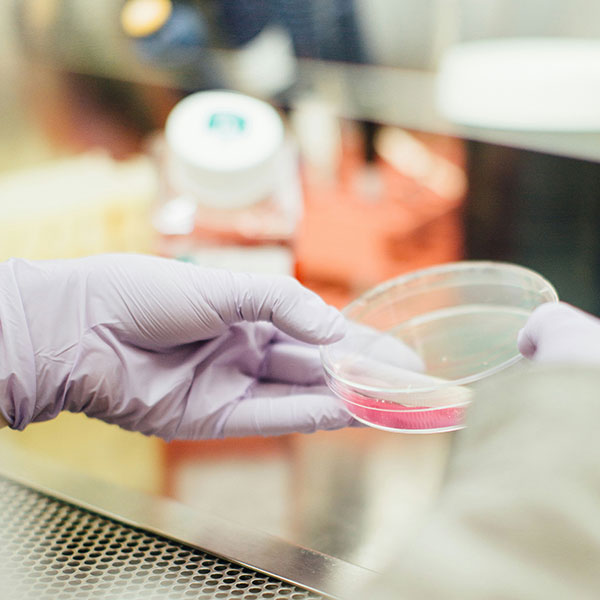
TYPO3 muko.info

Webentwicklung und Online-Marketing für Hilfsorganisationen, NGO
Internetagentur für Online-Fundraising
Vom Konzept über Design bishin zur Programmierung
Bereits seit Anfang der 2000er Jahre arbeitet fixpunkt für verschiedene Hilfsorganisationen projektbezogen oder kontinuierlich an der Weiterentwicklung ihrer Onlineaktivitäten.
fixpunkt kennt die spezifischen Anforderungen von NGOs
Sollen Spenden für Projekte gewonnen werden, sind Glaubwürdigkeit und Transparenz oberstes Ziel der Kommunikation. Hierzu gehört die ehrliche Darstellung und Offenlegung von:
- der jeweiligen Misson
- von Werten
- von Projekten und deren Ziel
- von der Verwendung der eingenommenen Mittel
- von beteiligten Partnern und Förderern.
fixpunkt entwickelt Werkzeuge für eine vielseitige und zielführende Kommunikation
Ehrliches und interessantes Storytelling bringt die Themen und Geschichten von Betroffenen nah an die Besuchenden heran. Hierzu gehören die gelungene Präsentation von (Spenden-)Projekten und Erfolgen sowie authentische Bild- und Videonutzung und die verständliche Darstellung von Impact („Was bewirkt meine Spende?“).
Vielseitige Spenden- und Engagement-Funktionen
Beim NGO-Webauftritt als zentralem Aktionsinstrument ist einfaches und sicheres Online-Spenden wesentlich. Empfehlenswert ist hier, auf externe Anbieter zurück zu greifen und deren Spendeformulare durch Schnittstellen zu implementieren. fixpunkt leitet Sie durch alle Anforderungen und bietet für Sie passende Lösungen.
Zum Engagement anregen
NGOs fördern das Mitmachen. Hierzu dienen u.a. Tools für ehrenamtliches Engagement und Petitionen, Darstellung und Anmeldemöglichkeit zu Events, Abonnement von Newslettern zu verschiedenen Themen.
Ethisch und rechtlich relevant - Barrierefreiheit
fixpunkt rüstet bestehende Webseiten so um, dass sie gegenüber dem Barrierefreiheitsstärkungsgesetz (BFSG) bestehen. Wichtigste Stichworte hierbei sind die Anforderungen von Screenreadern, Auszeichnung von Bildern, Tastaturnavigation, Untertitel für Videos.